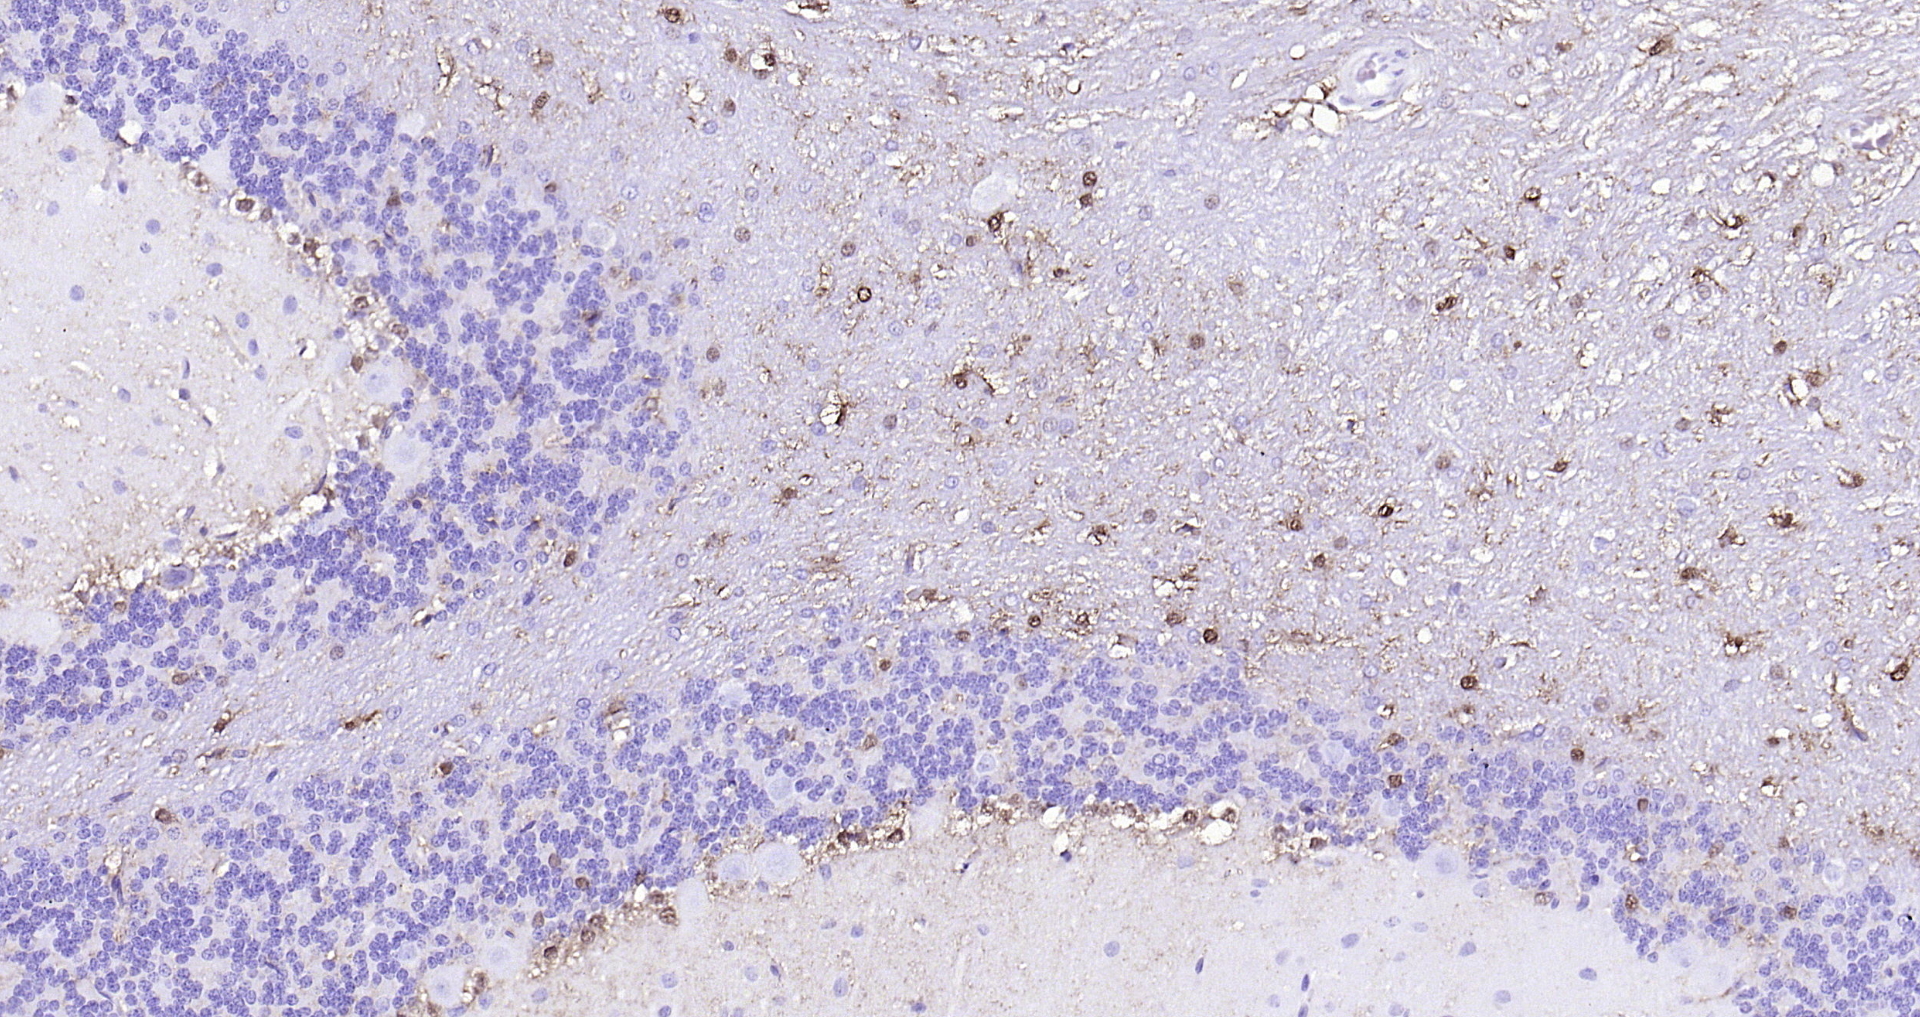
Paraformaldehyde-fixed, paraffin embedded (rat cerebellum); Antigen retrieval by boiling in sodium citrate buffer (pH6.0) for 15min; Block endogenous peroxidase by 3% hydrogen peroxide for 20 minutes; Blocking buffer (normal goat serum) at 37°C for 30min; Antibody incubation with (S100B) Monoclonal Antibody, Unconjugated (bsm-10832M) at 1:200 overnight at 4°C, followed by operating according to SP Kit(Mouse)(sp-0024 bs-0296G-HRP 1:300) instructionsand DAB staining.
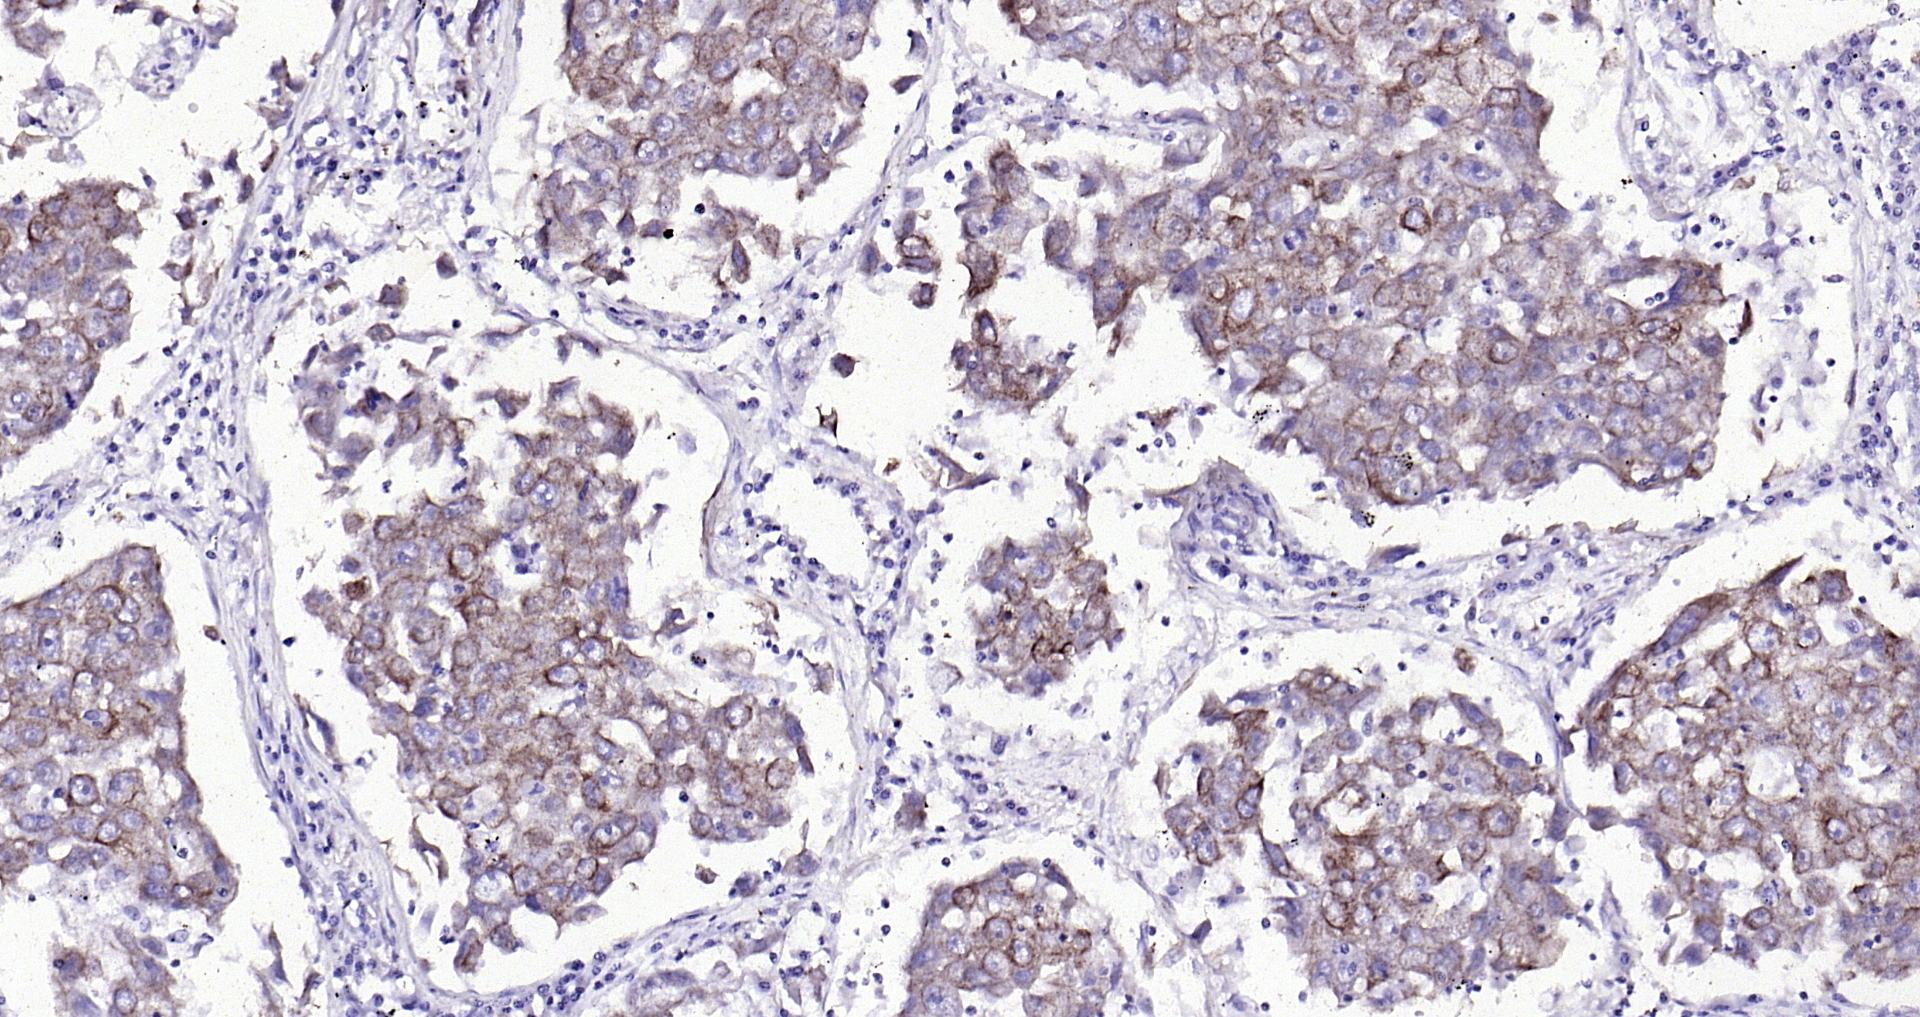
Paraformaldehyde-fixed, paraffin embedded (human lung carcinoma); Antigen retrieval by boiling in sodium citrate buffer (pH6.0) for 15min; Block endogenous peroxidase by 3% hydrogen peroxide for 20 minutes; Blocking buffer (normal goat serum) at 37°C for 30min; Antibody incubation with (Cytokeratin 8) Monoclonal Antibody, Unconjugated (bsm-33061M) at 1:200 overnight at 4°C, followed by operating according to SP Kit(Mouse)(sp-0024 bs-0296G-HRP 1:100) instructionsand DAB staining.

Paraformaldehyde-fixed, paraffin embedded (mouse brain); Antigen retrieval by boiling in sodium citrate buffer (pH6.0) for 15min; Block endogenous peroxidase by 3% hydrogen peroxide for 20 minutes; Blocking buffer (normal goat serum) at 37°C for 30min; Antibody incubation with (S100B) Monoclonal Antibody, Unconjugated (bsm-10832M) at 1:200 overnight at 4°C, followed by operating according to SP Kit(Mouse)(sp-0024 bs-0296G-HRP 1:100) instructionsand DAB staining.
Goat Anti-Mouse IgG Antibody (H+L), HRP Conjugated
BS-0296G-HRP
ApplicationsWestern Blot, ELISA, ImmunoHistoChemistry, ImmunoHistoChemistry Frozen, ImmunoHistoChemistry Paraffin
Product group Antibodies
ReactivityMouse
Overview
- SupplierBioss
- Product NameGoat Anti-Mouse IgG Antibody (H+L), HRP Conjugated
- Delivery Days Customer16
- ApplicationsWestern Blot, ELISA, ImmunoHistoChemistry, ImmunoHistoChemistry Frozen, ImmunoHistoChemistry Paraffin
- Applications SupplierWB(1:300-5000), ELISA(1:500-1000), IHC-P(1:200-400), IHC-F(1:100-500)
- CertificationResearch Use Only
- ClonalityPolyclonal
- Concentration1 ug/ul
- ConjugateHRP
- HostGoat
- IsotypeIgG
- ReactivityMouse
- Storage Instruction-20°C
- UNSPSC41116161
References
- Calcium Channels as Novel Therapeutic Targets for Ovarian Cancer Stem Cells. Lee H et al., 2020 Mar 27, Int J Mol SciRead this paper
- Cold Exposure-Induced Up-Regulation of Hsp70 Positively Regulates PEDV mRNA Synthesis and Protein Expression In Vitro. Kong F et al., 2020 Mar 26, PathogensRead this paper
- Codon optimization, expression in Escherichia coli, and immunogenicity analysis of deformed wing virus (DWV) structural protein. Fei D et al., 2020, PeerJRead this paper
- Phosphorus Restriction Changes the Expression of Fibroblast Growth Factor 23 and Its Receptors in Laying Hens. Ren Z et al., 2020, Front PhysiolRead this paper
- LINC00978 promotes hepatocellular carcinoma carcinogenesis partly via activating the MAPK/ERK pathway. Zhang Q et al., 2020 Mar 27, Biosci RepRead this paper
- Nanobody production can be simplified by direct secretion from Escherichia coli. Iwaki T et al., 2020 Jun, Protein Expr PurifRead this paper
- Kinesin family member 2C aggravates the progression of hepatocellular carcinoma and interacts with competing endogenous RNA. Zhang GP et al., 2020 Nov, J Cell BiochemRead this paper
- Activating the interleukin-6-Gp130-STAT3 pathway ameliorates ventricular electrical stability in myocardial infarction rats by modulating neurotransmitters in the paraventricular nucleus. Gao M et al., 2020 Feb 5, BMC Cardiovasc DisordRead this paper
- Ethanol extract of Ophiorrhiza pumila suppresses liver cancer cell proliferation and migration. Liu H et al., 2020, Chin MedRead this paper
- A Chimeric Sudan Virus-Like Particle Vaccine Candidate Produced by a Recombinant Baculovirus System Induces Specific Immune Responses in Mice and Horses. Wu F et al., 2020 Jan 3, VirusesRead this paper